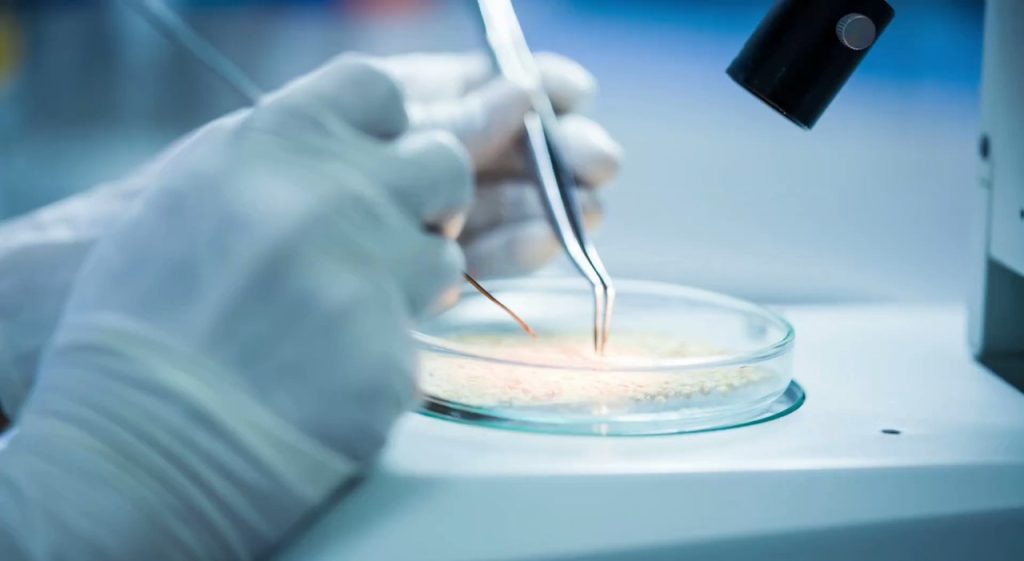
Scoperto interruttore molecolare che rallenta la progressione del tumore al seno.

Scoperto interruttore molecolare che rallenta la progressione del tumore al seno
Scoperta Rivoluzionaria sulla Proteina Shp1 e il Cancro
Un team di ricerca dell’Istituto degli endotipi in oncologia, metabolismo e immunologia del Consiglio Nazionale delle Ricerche (Cnr-Ieomi) di Napoli ha fatto una scoperta significativa riguardo alla proteina Shp1 nel contesto della progressione tumorale. Questo studio ha svelato una funzione inedita della proteina, precedentemente conosciuta solo come antagonista della crescita tumorale. Gli scienziati hanno dimostrato che Shp1 non solo regola l’aggressività dei tumori, ma agisce come un «interruttore» molecolare capace di influenzare diversi processi cellulari.
Il Ruolo Cruciale di Shp1 nell’Aggressività Tumorale
La proteina Shp1 ha la capacità di bloccare la cascata di segnali attivata dall’interleuchina 8 (IL-8), una sostanza prodotta dall’ambiente tumorale che stimola l’aggressività delle cellule cancerogene. Questa scoperta suggerisce che il controllo dell’espressione di Shp1 potrebbe avere un impatto diretto sulla capacità delle cellule neoplastiche di invadere tessuti e generare metastasi. L’aspetto innovativo di questa ricerca sta nella rivelazione che l’IL-8 può disattivare Shp1 attraverso una modificazione chimica, aprendo un meccanismo di autoregolazione finora sconosciuto.
Le ricercatrici sono entusiaste dei risultati ottenuti. Alessia Varone, coordinatrice dello studio, ha commentato: «Abbiamo identificato un modo completamente nuovo di come le cellule tumorali regolano il segnale di IL-8, influenzando la stabilità del suo recettore. Questo meccanismo non era mai stato descritto prima e apre la strada a nuove ricerche su altre proteine cruciali nell’ambiente tumorale».
Implicazioni Cliniche e Nuovi Obiettivi Terapeutici
La ricerca, pubblicata sulla prestigiosa rivista Cell Death & Disease, ha dimostrato che il meccanismo identificato è particolarmente attivo in due sottotipi di tumore mammario: i tumori luminali e i tumori triplo negativi. In questi ultimi, infatti, livelli ridotti di Shp1 sono associati a un’elevata produzione di IL-8 e a una prognosi meno favorevole. Queste scoperte suggeriscono che il meccanismo di autoregolazione di Shp1 possa fungere sia da marcatore della gravità della malattia che come target per terapie innovative.
Una caratteristica chiave di questo studio è la sinergia tra ricerca di base e applicazioni industriali, favorita dalla collaborazione con Dompé farmaceutici S.p.A. Questo link è fondamentale per garantire che le scoperte scientifiche possano tradursi rapidamente in applicazioni cliniche reali. Daniela Corda, una delle ricercatrici coinvolte, ha dichiarato: «I nostri dati suggeriscono che mirare a questo meccanismo potrebbe rappresentare un approccio innovativo nel contrasto ai tumori più aggressivi. Collaborare con l’industria farmaceutica è essenziale per accelerare il trasferimento delle conoscenze verso le pratiche cliniche».
In aggiunta al tumore al seno, l’interleuchina 8 riveste un ruolo importante in altri tumori solidi come quelli del polmone, pancreas e prostata. Queste informazioni testimoniano il potenziale applicativo della scoperta, aprendo a prospettive più ampie in oncologia.
Un Futuro Promettente nella Ricerca Oncologica
La scoperta del Cnr-Ieomi non è solo un avanzamento fondamentale nella comprensione della biologia tumorale, ma rappresenta anche un’opportunità per sviluppare strategie terapeutiche innovative. La possibilità di intervenire sui meccanismi di regolazione della proteina Shp1 offre nuove speranze per pazienti affetti da forme aggressive di cancro.
La ricerca continua a evolversi e questa scoperta potrebbe inaugurare un nuovo paradigma nella lotta contro il cancro. Con ulteriori studi e trial clinici, sarà possibile esplorare l’efficacia delle terapie mirate a Shp1 e IL-8, creando un impatto significativo nel trattamento dei tumori e nella qualità di vita dei pazienti.
Per rimanere aggiornati sugli sviluppi della ricerca oncologica e su ulteriori scoperte nel campo, gli esperti consigliano di seguire le pubblicazioni scientifiche e le news specializzate. Si invita anche a informarsi presso fonti ufficiali come il Consiglio Nazionale delle Ricerche e le riviste scientifiche accreditate.
Ultimo aggiornamento: giovedì 9 aprile 2026, 12:09
Fonte: Cnr-Ieomi, Cell Death & Disease
Non perderti tutte le notizie della categoria salute su Blog.it















